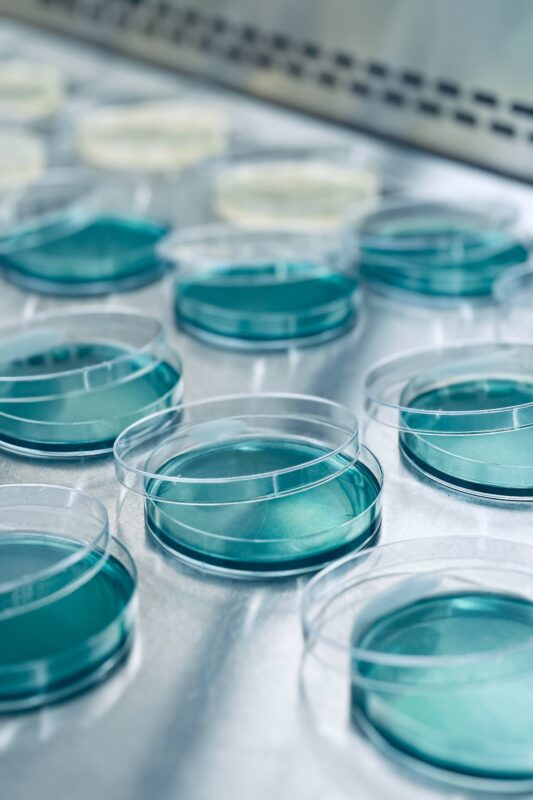

Title: Donde nace la Ciencia
Votes: ?
Category: Investigación Científica y Tecnológica
Views: ?
Description: Sin lugar de origen, cambiando, transformándose y evolucionado a través de distintas etapas, culturas y corrientes de pensamientos, con todas sus inexactitudes y aciertos, la ciencia no tiene un punto de partida, en consecuencia, no reconoce límites más que aquellos impuestos por los términos de lo inentendible aún, la naturaleza. Cada medio de cultivo Petri, dispuesto en un patrón ordenado dentro de la cámara nos hace pensar que el conocimiento más maravilloso puede alojarse donde nace una interrogante, vívida, llena de color, brillante como el celeste firmamento de este medio de cultivo. Fotografía obtenida desde una camara Fujifilm finepix s1600.